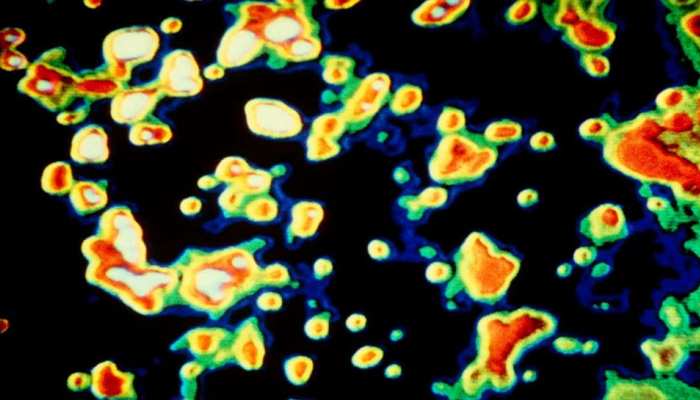

Preparation with Monthly Current Affairs 2021 will be very fruitful for the banking aspirants. Many bank exams either in Prelims or Mains, consists of questions from Current Affairs. Generally, six months of current affairs are advised to prepare to crack the upcoming bank exams. Here, we are providing you with the monthly current affairs pdf. In this pdf, you will get Current Affairs Summary ebooks for quick revision. Ebooks will give you the best way to read and revise important monthly current affairs before the exam in a short period. Monthly Current Affairs PDF can help you to score better in the general awareness section of various banking exams.
Contents
- First Blow Away Galaxy discovered
- BCCI suspends IPL 2021 indefinitely
- Crocidura narcondamica: New Shrew species found at A&N
- Mark Selby- World Champion for 4th time in Snooker
- Crimson Solar Project: US approves 550 million USD
- Guidelines issued for PLI Scheme for Food Processing Industry
- Putola Nach- Puppetry Art-form of Assam
- Indian Army’s First Green Solar Energy harnessing plant in Sikkim
- Odisha’s Gopabandhu Sambadika Swasthya Bima Yojana
- What is Significant Economic Presence (SEP) principle?
- UK-India $1.4 billion investment deal
- Congo declares the end of Ebola outbreak
- Uranium-214- The lightest form of Uranium
- IGST on Import of Oxygen Concentrators reduced
- Petroleum Minister Dharmendra Pradhan flags off the first supply of used cooking-oil based biodiesel
- EU proposes to ease travel restrictions on fully vaccinated tourists this summer
- Delhi Government announces free ration for 2 months, Rs. 5,000 each to autorickshaw drivers
- Jagmohan Former Governor Jammu and Kashmir passes away at 94
- Quiz
- Answers
First Blow Away Galaxy discovered

The astrophysicists from the Minnesota Institute for Astrophysics have discovered the first blow away galaxy using the “Gemini Telescope”. The galaxy has been named Pox 186.
Puzzles solved by the discovery
The Universe was in an ionised state when it was formed after the Big Bang. In this state, the electrons and protons moved freely and combined to form atoms and the water vapour condensed into clouds.
Scientists have observed that the Universe is back in its ionised state. Till now, the scientists were unable to find out how this happened. The discovery of blow away galaxy has solved this.
About Blow Away Galaxy
- According to scientists, the energy for reionisation must come from the galaxies themselves. However, it is hard for the light energy to escape a galaxy as the hydrogen clouds absorb the light. This is almost similar to that of the earth atmosphere absorbing sunlight.
- The Blow away state means that the hydrogen clouds have been removed. This allows light to escape.
- The Blow away state maybe was caused by dying stars, supernovas.
Blow Away Galaxy in simple Terms
The star formation is similar to that of blowing a balloon. If the star formation was intense, then there will be a rupture or hole made on the surface of the balloon. This happens to let out some energy. However, in the case of Blow Away Galaxy, the star formation was so powerful that the balloon was torn into pieces.
Gemini Telescope
It is an astronomical observatory that consists of two telescopes namely Gemini North and Gemini South. They are located in Hawaii and Chile respectively.
These telescopes are the largest and most advanced optical telescopes available to astronomers.
BCCI suspends IPL 2021 indefinitely

The Board of Control of Cricket (BCCI) has suspended the Indian Premier League (IPL) indefinitely due to COVID-19. The decision came in after Balaji tested positive for COVID-19. Balaji is the bowling coach of CSK.
So far twenty-nine games have been conducted. Also, the T20 World Cup is to be moved from India to UAE. This is mainly because if held in India none of the participants will be comfortable coming to India due to the third wave in the country.
BCCI
It is the governing body for cricket in India. Grant Govan was its first president. The total annual income of BCCI in 2020 was 535 million USD. This includes 345 million USD from IPL, 139 million USD from bilateral cricket with other nations and 405 million USD from India’s share of ICC revenue.
BCCI-Richest Board
In 2021, BCCI became the richest cricket board in the world. The revenue of BCCI increased exponentially after BCCI began the sale of media rights of the Indian team for ODIs, bilateral tests and T20 matches that are played inside the country.
The Star Network paid Rs 43.20 crore per international home match. In 2018-19, there were 22 test matches, Five T20s and ten ODIs. This added up to Rs 950.40 crores.
Another major source of income for the BCCI is the sponsors for the national team.
Revenue system
In 2014, a new contribution-based revenue distribution was adopted. This system was adopted by BCCI along with England and Wales Cricket Board. However, the system was dismantled by ICC (International Cricket Council) which eventually reduced the revenue of BCCI.
Crocidura narcondamica: New Shrew species found at A&N

A team from the Zoological Survey of India has discovered a new insect-eating mammal species. The animal has been named Crocidura Norcondamica.
About Crocidura Norcondamica
It is almost the size of the house mouse. It lives on the forest floor and feeds on insects. They help to control the insect population in the dense Narcondam forest.
It belongs to the Shrews family. Shrews are not rodents.
Insect Eating Mammal
A new insect-eating mammal species have been discovered in India after four years. The last insect-eating mammal to be discovered in India was Jenkin’s Andaman shrew. It was discovered in 1978 on South Andaman Island.
The recently found Crocidura Norcondamica has been named after the Norcondam Island of the Andaman and Nicobar Islands. It was found in Norcondam Island.
To date, around 422 mammal species have been reported in India.
Norcondam Island
It is a small volcanic island located in the northern Andaman sea. It is formed of Andesite. It is 124-kilo metres away from the main body of the Andaman and Nicobar Islands. The island was classified as a dormant volcano by the Geological Survey of India.
Burma claimed the sovereignty of the island till 1986. It gave up the claim after reaching an agreement with India on the delimitation of the maritime boundary. According to the agreement, the countries drew their maritime boundary in the Coco channel, Andaman sea and Bay of Bengal.
The Narcondam hornbill is endemic to the island and is endangered.
The Narcondam Wildlife Sanctuary has been listed on the tentative list of World Heritage sites of UNESCO. The island was notified as a Wildlife sanctuary mainly to protect the hornbill.
Mark Selby- World Champion for 4th time in Snooker

The English professional Snooker player Mark Selby has won the World Championship for the fourth time. This time he won the title defeating Shaun Murphy.
Mark Selby
- Mark Selby has won the World Championship in 2014, 2016, 2017 and 2021.
- He was ranked world number one between 2015 and 2019.
World Snooker Championship
It is being held since 1927 annually. It is played at the Crucible Theatre in Sheffield, England. The World Professional Billiards and Snooker Association organise the championship.
About Snooker
It is a cue sport. Cue Sport is also called Billiard sports. They are a wide variety of games that are played with a cue stick. It played on a table with four pockets or six pockets. It is played using snooker balls and a cue.
The objective of the snooker game is to hit the white cue ball with the cue so that it strikes the other balls and in turn, they fall into the pockets. The player who scores more points in the game wins. The balls are of different colours and each colour has different point.
Fouls in Snooker Game
The following are the fouls in the snooker game:
- Failing to hit any ball
- Potting the cue ball
- Touching other balls with anything other than a cue ball
- Making a ball fall off the table
- Push Shot: It is a shot where the object ball in direct contact with the cue ball moves when the cue ball is hit
- Jump Shot: It is a shot where the cue ball jumps over a ball before hitting another ball
- Playing the shot both feet off the ground. The player might lean over the table. However, at least one leg should be on the ground.
Crimson Solar Project: US approves 550 million USD

The United States recently approved 550 million USD for the Crimson Solar Project. The project will provide electricity to 87,500 homes.
About Crimson Solar Project
- The project is to be set up on 2,000 acres of land in the Desert of California.
- The project site is 13 miles west of Blythe.
- The project will be owned by Sonoran West Solar Holdings LLC.
- The construction of the project is to provide 650 temporary jobs. Also, it will provide forty temporary jobs and ten permanent jobs.
- It features 350 MW of solar photovoltaic facility and 350 MW of energy storage system.
- It is a part of Biden’s plan to accelerate the development of renewable energy on public land and water.
Solar Energy in the US
As of 2020, the United States had 97,275 MW of installed concentrated and photovoltaic solar power. This is 1.66% of the total electricity consumed by the country.
Biden’s Plan
The US President Joe Biden signed a 2 million USD of infrastructure proposal to curb Greenhouse gas emissions in the US. The plan also proposed 100 billion USD to update the electric grid system in the country and make it more resilient to climate disasters.
During the Leaders Summit on Climate hosted by the US, the President announced that the US will achieve net-zero emissions by 2050.
California Desert
There are three main deserts in California. They are the Colorado Desert, Mojave Desert and the Great Basin Desert. The Colorado Desert lies in the northwest of the Californian Desert. The Great Basin Desert is the only cold desert located in the country.
The Mojave Desert includes San Gabriel and San Bernardino mountain ranges. These mountains are outlined by the two largest faults in California called the Garlock Fault and San Andreas Fault.
Guidelines issued for PLI Scheme for Food Processing Industry

The Government of India recently issued guidelines for the “Production Linked Scheme” of the Food Processing Industry. The GoI had earlier approved the PLI Scheme for Food Processing under the “Atma Nirbhar Bharat” with an outlay of 10,900 crores of rupees. The scheme is to be implemented between 2021-22 and 2026-27.
Categories in the Guidelines
The Guidelines has divided the applicants of the scheme into the following categories:
Category 1: These applicants are large entities who apply for Incentive based on Sales and Investment criteria. These applicants shall undertake branding and marketing activities abroad. They shall also apply for a grant.
Category 2: These applicants belong to Small and Medium enterprises. They manufacture innovative products. They apply for the grant under the scheme based on their sales
Category 3: These are applicants who apply for a grant to undertake branding and marketing activities abroad.
Guidelines
- The sale-based incentive under the PLI scheme shall be paid for six years between 2021-22 and 2026-27.
- The base year to calculate incremental sales will be 2019-20 and the base year for the fifth and sixth year is to be 2021-22 and 2022-23 respectively.
- The grant provided on branding and marketing shall be extended to 50% of the expenditure. The maximum grant allowed is 3% of sales on food products or 50 crores of rupees per year (whichever is less).
Selection of applications
The following guidelines have been provided for selecting the applicants:
- The Category I applicants are selected based on their sales, committed investment and exports. There are four product segments that are to be incentivised under the scheme. They are ready to cook or ready to eat including millet-based foods, marine products, processed fruits and vegetables and mozzarella cheese.
- The applicants under Category II are selected based on their innovative proposal, uniqueness of the product, etc.
- The applicants under Category III are selected based on the level of recognition of their brand, plan for production, strategy, sales, export markets, etc.
Putola Nach- Puppetry Art-form of Assam

A trust-based in Assam recently made videos using the traditional art called “Putola Nach”. The art form was used to take the messages related to COVID-19 to the public through social media.
The videos were produced in collaboration with UNICEF. The names of the videos were COVID Shatru (enemy), COVID Bibharat (confusion). These two were released in Assamese. Mama ro Mina ko COVID Katha (COVID Tale of Mama and Mina) was released in the Nepali language.
Putola Nach
- It is a traditional string puppet theatre from Assam in North East India.
- The other forms of puppetry and shadow theatre have disappeared.
- The Putala nach is also called putala bhaona.
- Usually, Putola Nach is used to perform scenes from the epics such as Ramayana or Mahabharatha.
- These dolls are 1.5 metres tall and are made of hollow wood or bamboo. Their heads are made of terracotta.
- Musical Instruments used in performing the art are dhol, harmonium, kansi, double-reed wind instrument and a bell metal plate beaten with a stick.
- There were three different styles of string puppetry in Assam. They were Kalaigaon in Northern Assam, Barpeta-Nalbari in western Assam and Majuli “island” in eastern Assam.
Tholpavakoothu
- It is a shadow leather puppet play.
- In February 2021, it was animated by a robot.
- It is a fine example of the integration of Dravidian and Aryan cultures.
- It is also called Olakoothu and Nizhalkoothu.
- The Musical instruments used in the art are Chenda, Ezhupara and Maddalam.
- The Chief puppeteer of the art is known as “Pulavan”.
Indian Army’s First Green Solar Energy harnessing plant in Sikkim
![]()
The Indian Army recently launched the first Green Solar Energy harnessing plant in Sikkim. It was launched to benefit the troops of the Indian army.
About the plant
- The plant uses Vanadium based battery technology.
- It was built at an altitude of 16,000 feet.
- The capacity of the plant is 56 KVA.
- It was completed in collaboration with IIT Mumbai.
Other green initiatives of the Indian Army
- The Indian Army recently (April 2021) launched a solar power plant at Jalandhar Cantonment. It was launched on World Earth Day. Also, it was launched as a part of the “Go Green” initiative.
- The plant was constructed at a cost of Rs 5.16 crores.
- It was dedicated to the military hospital in the cantonment.
- The plant was set up on five acres of land.
- The project has installed 3,176 solar panels of Indian origin to produce 1MW of solar energy.
- It is expected that the project will produce 15 lakh units of solar power annually and will help save Rs 1 crore per year.
Vanadium
- In January 2021, Vanadium was discovered in Arunachal Pradesh. This was the first discovery of Vanadium in India.
- India consumes 4% of global vanadium production in the world.
- It is found in sixty different minerals and ores that includes carnotite, vanadate, roscoelite, patronite.
- Vanadium is used in making steel alloys, space vehicles, nuclear reactors, etc. It is also used in making girders, piston rods. Vanadium redox batteries are used in superconducting magnets. They are also used to create reliable renewable sources of energy.
- The colour of Vanadium is silver. It is a transitional metal, that is, a good conductor of heat and electricity.
Odisha’s Gopabandhu Sambadika Swasthya Bima Yojana
The Chief Minister of Odisha Naveen Patnaik recently declared working journalists of the State of Odisha as the frontline COVID-19 warriors. This announcement was made under the Gopabandhu Sambadika Swasthya Bima Yojana. With these more than 6,500 journalists are to be benefitted from the state.
Gopandhu Sambadika Swasthya Bima Yojana
- It is a health insurance scheme that was introduced for the journalists by the Odisha state government. The scheme provides two lakh rupees of health insurance cover to all the working journalists of the state.
- It was launched in 2018.
- The scheme includes cashless treatment in government and private hospitals.
- It also covers illness and injuries faced by journalists while performing their duties.
Gopalbandhu Das
- The scheme has been named after Gopalbandhu Das. He was a popular reformer, social worker, journalist, political activist, essayist and poet in Odisha.
- His contributions to the field of culture, art and society earned him the “Epithet of Utkalmani”. It means the Jewel of Odisha.
- He launched a magazine called “Satyabadi”. His contributions to journalism were short but remarkable.
Other states
Several other states also declared journalists as frontline workers. This includes Madhya Pradesh, Bihar, Punjab, West Bengal, Tamil Nadu, Uttarakhand, Uttar Pradesh.
Significance
The significance of declaring journalists as frontline workers are that they will be vaccinated in Phase I of the COVID-19 vaccination programme of India. The beneficiaries of phase I of the COVID-19 vaccination programme are health care workers, frontline workers and those in the population greater than fifty years. The current frontline workers are home guards, armed forces, prison staff, municipal workers, civil defence volunteers including disaster management volunteers.
What is Significant Economic Presence (SEP) principle?

India recently notified the Digital Tax threshold of two crore rupees and 300,00 users under the Significant Economic Presence principle. This threshold was notified for non-resident technology firms such as Netflix, Facebook, Google, to pay tax in India. The principle was first introduced in the Finance Bill 2018-19.
It was adopted to address the challenges of tax profits made by digital companies.
What is Significant Economic Presence?
It means that a transaction in goods or services or property carried out by a Non-Resident in India. This includes the download of software or data. In June 2019, Finance Minister Nirmala Sitharaman called on the G-20 countries to adopt the “Significance Economic Presence”.
Background
The Significant Economic Presence concept was introduced in 2018 under Income Tax Act, 1961. It was basically introduced to tax the income of non-residents. These incomes are those related to goods and services or property in India.
The inception of Significant Economic Presence
In 2015, the Organisation of Economic Cooperation and Development (OECD) issued fifteen Base Erosion and Profit Shifting (BEPS) Action Plans (AP). The BEPS-AP 1, that is, the first report of BEPS-AP is about tax challenges in the digital economy. It stated that it is important to examine enterprises that earn profit in the digital economy.
Apart from Significant Economic Presence, the BEPS-AP also analysed several other challenges. This includes Equalisation Levy that was implemented in 2016 in India.
What is Equalisation Levy?
It was introduced to tax business to business transactions that happen digitally. This mainly targeted at taxing the income accruing to foreign e-commerce companies from India. Accruing is someone receiving money at an increasing rate over time.
UK-India $1.4 billion investment deal

The Government of India and the British Government recently finalised a one billion pound of trade and investment with India. This is expected to create 6,500 jobs in the UK. The deal has been finalised ahead of the virtual summit between Indian Prime Minister Narendra Modi and UK Prime Minister Boris Johnson. The leaders will sign the deal formally during the summit. The summit is to be held on May 4, 2021.
About the new investment deal
- The deal is a part of the Enhanced Trade Partnership. The Enhanced Trade Partnership is to be signed between leaders during the summit.
- The Enhanced Trade Partnership will lift restrictions to enable fruit producers across the UK to export pears, British Apples and quince to India for the first time.
- The partnership will also include acceptance of UK certification of Free sale in India. This will remove the additional accreditation of UK medical devices in exporting to the Indian market.
- Under the partnership, the countries will commit to deepening cooperation in educational services. With this, the student flows and skill transfer between the countries will increase.
- It will set an ambitious target of doubling the trade between the UK and India by 2030.
- It has also declared a shared intent to start the base work towards a comprehensive Free Trade Agreement.
- It also covers export deals of more than 446 million Great British Pounds. This is to create more than 400 British jobs.
The trade between India and UK is 23 billion Great British Pounds a year. This is supporting more than half a million jobs a year.
Trade and Investment package of UK
The British Government recently unveiled 533 million Great Britain Pounds of Indian investment into the United Kingdom. This covers areas such as technology and health care. It also includes the 240 million Great Britain Pounds of investment to be made by the Serum Institute of India in the UK. The Serum Institute is to further expand its business to 1 billion USD in Britain.
Way Forward
India and UK will sign a trade deal in the future that will remove current tariffs on whiskey up to 150% and on automotive up to 125% in India.
Congo declares the end of Ebola outbreak

The Democratic Republic of Congo recently declared the end of the twelfth outbreak of Ebola. It had killed six people in the eastern province of North Kivu.
About Ebola Outbreak
- The current Ebola outbreak was genetically linked to that of the outbreak that occurred in 2018-20.
- Currently, Guinea is also fighting against the Ebola epidemic.
- The Ebola virus was discovered in 1976. The 2014-16 outbreak of Ebola in West Africa is the largest Ebola outbreak since its discovery.
- In June 2019, the World Health Organisation declared outbreak in the Democratic Republic of Congo as Global Health Emergency.
Global Health Emergency
The Global Health Emergency is declared when a disease outbreak is risk to other countries. It requires a coordinated international response.
Ebola virus
- The Ebola virus transmits from wild animals to people. It spreads among human population through human-to-human population.
- The natural hosts of Ebola virus are the fruit bats.
- The methods used to diagnose Ebola are ELISA, Serum neutralization test, electron microscopy, virus isolation by cell culture, reverse transcriptase polymerase chain reaction (RT-PCR), antigen capture detection tests.
- The fatality rate of Ebola is 50%.
In 2019, WHO declared Ebola as one of the top ten threats to Global Health in 2019. The other threats were non-communicable diseases, air pollution, climate change, global influenza pandemic, anti-microbial resistance, weak primary health care, vaccine hesitancy, HIV, and fragile and vulnerable settings.
Ebola Vaccines
- rVSV-ZEBOV was an Ebola vaccine used in Guinea in 2015.
- It was also used during 2018-19 Ebola outbreak in Congo.
- The vaccine is administered to pregnant women and breastfeeding women under the same condition as that of the general population.
Uranium-214- The lightest form of Uranium
Scientists have recently created the lightest form of Uranium. It is called the Uranium-214. The discovery reveals more information about an alpha particle. The alpha particle is those particles that gets ejected from radioactive elements as they decay.
About Uranium-214
This isotope of Uranium has a greater number of neutrons than protons. The neutrons have mass. However, Uranium-214 found recently is much lighter than the other common Uranium isotopes. This includes Uranium-235 as well. Uranium-235 is the most commonly used isotope. It has 51 extra neutrons.
Uranium-214 was created at the Heavy Ion Research Facility in Lanzhou, China.
It had a half-life of just half a millisecond. The half-life of a radioactive sample is the time taken for half of the radioactive sample to decay. The half-life of Uranium-238 is 4.5 billion years. This is almost equal to the age of the earth.
Alpha Decay in Uranium-214
The new isotope found also showed unique behaviours during its decay. This new finding will help scientists understand the radioactive process called Alpha decay.
In alpha decay, the atomic nucleus loses two protons and two neutrons. They are collectively called alpha particle. Scientists are yet to find the answers on how these alpha particles are ejected.
How was Uranium-214 created?
A beam of Argon was projected on Tungsten inside a Gas-filled recoil separator. The researchers then added protons and neutrons to the material through a LASER beam to create Uranium-214.
Nuclear force in Uranium-214
The scientists found that protons and neutrons of Uranium-214 interacted much more strongly than in isotopes with a similar number of neutrons and protons. In other words, the nuclear force in Uranium-214 was greater than the nuclear force in other isotopes.
IGST on Import of Oxygen Concentrators reduced

The Ministry of Finance recently cut the IGST on import of oxygen concentrators for personal use to 12%. Earlier it was 28%. IGST is Integrated Goods and Services Tax. The decision was announced by the Central Board of Indirect taxes and Customs.
The changes are being made in accordance to the IGST Act, 2017.
Constitutional Provisions
Article 286
Under the article, no states are allowed to impose tax on the purchase or sale of goods in the following:
- Import of Export of Goods
- Every sale or purchase that is happening outside the state
Article 269
The following taxes shall be collected by the Central Government by assigning it to the State Government:
- Taxes on Properties other than agricultural land
- Taxes on Railway fares and freights
- Tax on goods or passengers carried by sea, air or railways
- Taxes on stamp duties on transaction in stock exchanges
- Estate duty on property other than agricultural land
- Taxes on consignment of goods
- Taxes on sale or purchase of goods other than newspapers
Background
As the second wave of COVID-19 in increasing in the country, The Government of India recently allowed import of oxygen concentrators for personal use. This shall be done through E-Commerce portals or gift category. In order to achieve this Oxygen Concentrators were included in gift category.
Legal provisions
The Import of Oxygen Concentrators for personal use was allowed by amending Foreign Trade Policy (2015-20). In 2020, GoI extended the Foreign Trade Policy till 2021.
Recent measures by GoI to increase Oxygen supply in the country
- PM CARES Fund: Oxygen Plant for 100 new hospitals
- Pressure Swing Adsorption Plants to increase oxygen
- DRDO develops Supplemental Oxygen Delivery System
- Indian Railways runs Oxygen Express
- Basic customs duty and health cess on medical oxygen, equipment launched
- Import of 10,000 Oxygen Cylinders
- WHO to provide 4,000 oxygen concentrators to India
- PM CARES Fund: 1 Lakh Portable Oxygen Concentrators
- Import of Oxygen concentrators for personal use permitted
- Operation Samudra Setu II launched
Petroleum Minister Dharmendra Pradhan flags off the first supply of used cooking-oil based biodiesel

The Petroleum Minister Dharmendra Pradhan on May 4, 2021, flagged off the first supply of Used Cooking Oil- UCO-based biodiesel blended diesel from the Tikrikalan Terminal of Indian Oil. The supply has been launched under the Expressions of Interest (EoIs) Scheme.
The Union Minister while speaking on the occasion complimented the oil industry for its role in keeping the fuel lines running despite the pandemic. He also lauded the OMCs for extending support for the medical oxygen supply to the nation amid the ongoing crisis.
While referring to the flag-off of the first-ever supply of UCO-based biodiesel, the minister stated that this step is a landmark in India’s pursuance of biofuels and that this will have a positive impact on the environment.
Objective:
The Petroleum Minister informed that this initiative will provide substantial economic benefits to the country by boosting the indigenous biodiesel supply, generating rural employment, and reducing import dependence.
Expression of Interests (EoI) Scheme:
• In order to create an ecosystem for the conversion and collection of UCO into biodiesel and developing entrepreneurship opportunities, the minister of Petroleum and Natural Gas in collaboration with the Minister of Health, Science and Technology, and Earth Sciences had initiated the Expression of Interest.
• It was launched for the procurement of Bio-diesel produced from the Used Cooking Oil- UCO on August 10, 2019.
• Oil Marketing Companies periodically release such ‘Expression of Interest’. The Union Petroleum Minister while appreciating the role of Oil Marketing Companies shared that 30 LOIs (Letter of Intent) have already been issued.
• In the first phase of the scheme, 11 Expression of Interests were floated between August 10, 2019, to November 9, 2020, for 200 locations.
• Publications of such EOIs have been extended for one more year up to December 31, 2021, for 300 locations all over the country.
• OMCs, under the initiative, also offer periodically incremental price guarantees for 5 years. They also extend off-take guarantees for the period of 10 years to prospective entrepreneurs.
Biodiesel: An alternative fuel
Biodiesel is an alternative fuel that is similar to fossil diesel. Biodiesel can be produced from animal fats, vegetable oil, and waste cooking oil.
A major advantage of Biodiesel is its carbon-neutrality, meaning that the oilseed absorbs the same amount of CO2 as is released when the fuel is combusted in a vehicle. Biodiesel is also completely non-toxic and is biodegradable.
EU proposes to ease travel restrictions on fully vaccinated tourists this summer
The executive of the European Union has recommended easing the COVID-19 travel restrictions in June 2021 to let foreign travellers from more countries enter the bloc. The EU hopes to boost the stricken tourist industry in the summer of 2021.
Under the current restrictions by the EU, the travellers from only seven countries, including Singapore and Australia, are allowed to enter the EU on holiday, regardless of whether they have been vaccinated but must confirm to tests or quarantine.
The new proposal from the EU Commission, which will still require approval by the 27 member states of the EU, will allow the fully vaccinated foreign tourists and those from the nations with a ‘good epidemiological situation’.
In a tweet, the President of the European Commission stated that it is time to revive the tourism industry and for the cross-border friendships to rekindle.
EU member states to discuss the proposal:
The member states of the European Union are due to start discussing the proposal soon and the officials hope that it will be approved in May 2021, as the EU plans to pass the proposal before the mass summer travel starts.
Travellers arriving from Russia, Britain and a number of other nations will meet the new criteria, as per the data provided by the Centre for Disease Control and Prevention. The citizens of the United States will not currently do so.
EU suffers a big loss due to COVID-19:
The travel restrictions announced because of the widespread COVID-19 pandemic have inflicted heavy losses on the tourism industry in the European Union.
If the member states agree on the new proposals, specific European Union countries will be expected- but not be legally obliged- to follow the new joint approach to revive travel. Greece has already permitted vaccinated tourists from Israel.
Measures proposed by EU to revive tourism industry:
• Other measures include a central European Union register. It will allow free travel for the bloc’s travellers holding a ‘green certificate’ which proves that they have been vaccinated, have immunity after recovering or have tested negative for the COVID-19 test.
• The EU Commission has also recommended allowing the citizens who are fully vaccinated with EU-recognised vaccines to be able to enter from any nation. The commission also stated that other vaccines can be added if they are approved by WHO.
• Currently, the European Medicines Agency has given authorization to the use of shots of Moderna, Pfizer, AstraZeneca and Johnson & Johnson in the EU.
• The EU Commission has also proposed a ‘new emergency brake’, to limit the risk of importing new COVID variants. The brake will allow swift travel restrictions from those countries where the health situation collapsed sharply. European Union Countries will review the situation every two weeks.
Delhi Government announces free ration for 2 months, Rs. 5,000 each to autorickshaw drivers

The Delhi state government announced on May 4, 2021, that it will provide free ration to all the ration cardholders in the state for the next two months and Rs. 5,000 each to all the taxi and autorickshaw drives in the state.
The decision has been taken as the government decided to extend the ongoing lockdown in the state till May 10, 2021.
As per the Chief Minister of Delhi Arvind Kejriwal, the imposition of lockdown was required to control the spread of the virus and for breaking the COVID-19 chain. However, he added, that the lockdown can create financial difficulties for the underprivileged sections of the state, particularly the daily wage labourers.
In 2020, the Arvind Kejriwal government had also helped around 1,56,000 taxi drivers and autorickshaw drivers.
Delhi extends help to those in need:
The Chief Minister of Delhi Arvind Kejriwal informed that the government has decided that all the ration cardholders in the state, around 72 lakh, will be given free ration for two months.
He further added that it does not mean that the lockdown will continue for two months and that it is done to help the poor going through the financial crisis.
The CM also announced that all the taxi drivers and autorickshaw drivers will be given Rs. 5,000 each by the state government. This will help them in going through the ongoing financial crisis.
Delhi Government provides financial aid to construction workers:
The Arvind Kejriwal government had also disbursed ex-gratia payments of Rs. 5,000 each to the construction workers who have been registered under the Delhi building as well as other construction workers' welfare boards.
The Chief Minister has urged all the political parties and people to help each other without doing any form of politics. He added that if we all fight together, we will be able to win the fight against the pandemic.
COVID-19 cases in Delhi:
On May 3, 2021, Delhi has reported 18,043 new infected cases and 448 deaths. This is also the single -highest death toll in the city since the COVID-19 pandemic broke out in 2020. The total active cases in Delhi now are 89,592.
Jagmohan Former Governor Jammu and Kashmir passes away at 94

Jagmohan, former Governor of Jammu & Kashmir, passed away at 94 after battling a brief period of illness in Delhi on May 3, 2021.
Prime Minister Narendra Modi expressed his grief over the death of the former Governor (J&K) and called it a ‘monumental loss for the nation’.
Home Minister Amit Shah also tweeted a picture of Jagmohan to share his deepest condolences on the demise of the former Governor (J&K).
About Jagmohan, former Governor (J&K)
Jagmohan Malhotra was more known as Jagmohan. Born on September 25, 1927, He served as a former civil servant and held posts of the Governor of Jammu & Kashmir and Goa, and Lieutenant Governor of Delhi.
Jagmohan served as the Governor of J&K two times, the first term from 1984, and the second term from January to May 1990.
He got elected to the Lok Sabha for the first time in 1996 and held the post of the Union Minister for Urban Development and Tourism.
Jagmohan was honoured with the three highest civilian awards:
•In 2016, he was awarded the Padma Vibhushan, the second-highest civilian award, and
•In 1977, he was awarded the Padma Bhushan, the third-highest civilian award, and
•In 1971, he was awarded the Padma Shri, the fourth-highest civilian award.
Quiz
What is the name of the first blow away galaxy?
- Messier 82
- Andromeda I
- NGC 5866
- IC 342
- POX 186
Where is Gemini Telescope located?
- Hawaii
- Chile
- Japan
- China
- Both 1 & 2
Who suspended the Indian Premier League (IPL) due to Covid 19?
- ICC
- BCCI
- BPL
- ICB
- Indian Sports Ministry
Who is the governing body for cricket in India?
- ICC
- BCCI
- BPL
- ICB
- Indian Sports Ministry
What is the name of the new insect-eating mammal species by the Zoological Survey of India?
- Crocidura Norcondamica
- Neomys fodiens
- Crocidura russula
- Neomys anomalus
- Crocidura suaveolens
Norcondam Island is a part of ____ group of islands.
- Andaman and Nicobar Islands
- New Guinea
- Hawaiian Islands
- Caroline Islands
- Lakshadweep Islands
Who has Mark Selby defeated to win the Snooker World Championship for the forth time?
- Shaun Murphy
- Judd Trump
- Mark Allen
- Neil Robertson
- Ding Junhui
What is the proposed site for Crimson Solar Project?
- California
- Sikkim
- Leh
- Blythe
- Arizona
Putola Nach is a traditional art form of ____.
- Odisha
- Assam
- Maharashtra
- Arunanchal Pradesh
- Goa
Who is the Cheif Minister of Odisha?
- Y. S. Jaganmohan Reddy
- Pema Khandu
- Sarbananda Sonowal
- Bhupesh Baghel
- Naveen Patnaik
Who among the following was declared as the frontline COVID-19 warriors by the State of Odisha?
- Teachers
- State Volunteers
- Public Cleaning Staff
- Journalists
- Lawyers
When was the Significant Economic Presence principle first introduced in India?
- The Finance Bill 2010-11
- The Finance Bill 2018-19
- The Finance Bill 2020-21
- The Finance Bill 2012-13
- The Finance Bill 2016-17
Which among the following country has declared an end to Ebola Outbreak?
- Guniea
- Congo
- India
- Madagascar
- Nigerea
What is the lightest form of Uranium?
- Uranium-214
- Uranium-72
- Uranium-18
- Uranium-52
- Uranium-1
Jagmohan Malhotra is the former governor of ____.
- Telangana
- Mizoram
- Jammu & Kashmir
- Assam
- Tamil Nadu
Answers
What is the name of the first blow away galaxy?
- POX 186
Where is Gemini Telescope located?
- Hawaii
- Chile
- Both 1 & 2
Who suspended the Indian Premier League (IPL) due to Covid 19?
- BCCI
Who is the governing body for cricket in India?
- BCCI
What is the name of the new insect-eating mammal species by the Zoological Survey of India?
- Crocidura Norcondamica
Norcondam Island is a part of ____ group of islands.
- Andaman and Nicobar Islands
Who has Mark Selby defeated to win the Snooker World Championship for the forth time?
- Shaun Murphy
What is the proposed site for Crimson Solar Project?
- California
Putola Nach is a traditional art form of ____.
- Assam
Who is the Cheif Minister of Odisha?
- Naveen Patnaik
Who among the following was declared as the frontline COVID-19 warriors by the State of Odisha?
- Journalists
When was the Significant Economic Presence principle first introduced in India?
- The Finance Bill 2018-19
Which among the following country has declared an end to Ebola Outbreak?
- Congo
What is the lightest form of Uranium?
- Uranium-214
Jagmohan Malhotra is the former governor of ____.
- Jammu & Kashmir
0 Comments